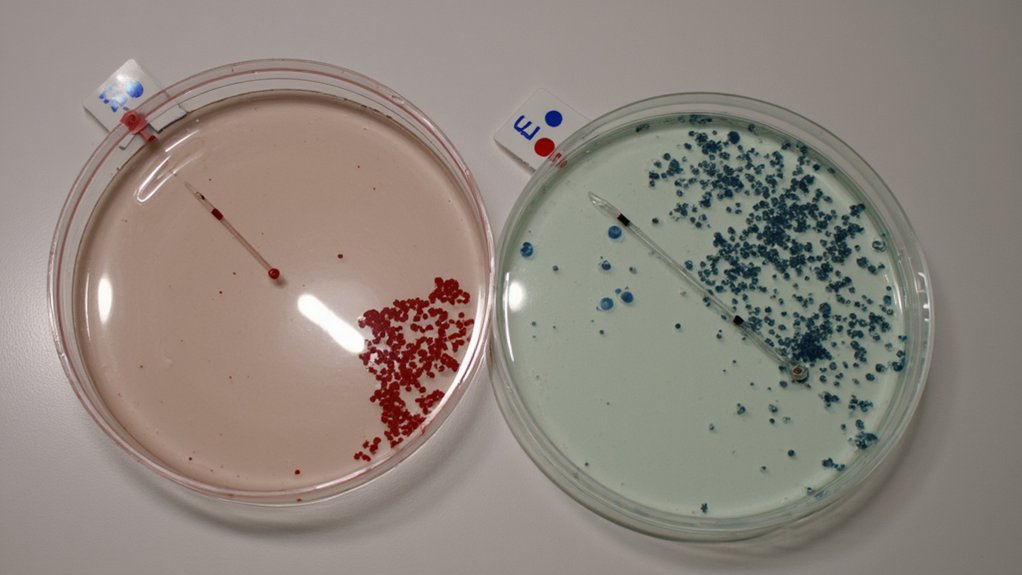

You might be surprised to learn that cold air doesn’t actually kill germs in your home – in fact, it can help them survive longer. According to Dr. Sarah Collins, microbiologist at Stanford University: “Many viruses and bacteria thrive in colder temperatures, with flu viruses becoming more stable below 40°F.” Understanding how temperature affects different pathogens will help you develop more effective strategies for maintaining a genuinely germ-free environment in your living space.
The Science Behind Temperature and Bacterial Growth
While many people believe cold temperatures kill germs, the relationship between temperature and bacterial growth is more complex than you might think. Bacteria don’t actually die in cold temperatures – they just become dormant and slow their bacterial metabolism.
Most bacteria thrive between 40°F and 140°F (4-60°C), which scientists call the “danger zone.” When temperatures drop below these temperature thresholds, bacteria enter a survival state but don’t die. You’ll find that:
- Freezing temperatures (32°F/0°C) pause bacterial growth
- Refrigeration (40°F/4°C) considerably slows reproduction
- Room temperature (68-72°F/20-22°C) allows active growth
That’s why your refrigerator keeps food fresh but doesn’t sterilize it, and frozen foods can still harbor bacteria that reactivate once thawed.
Common Misconceptions About Cold Air and Germs

Many people mistakenly think that cold winter air kills germs, but this popular belief doesn’t match the scientific evidence. In fact, cold air can actually help some bacteria and viruses survive longer.
Common misconceptions about cold air and germ survival include:
- Believing that freezing temperatures automatically kill bacteria
- Assuming cold outdoor air will sanitize indoor spaces
- Thinking that opening windows in winter eliminates germs
Dr. Sarah Miller, microbiologist at Stanford University, explains: “Cold air typically preserves microorganisms rather than destroying them. Many pathogens have evolved to survive in low temperatures.”
Instead of relying on cold air to kill germs, you should:
- Maintain proper ventilation year-round
- Use appropriate disinfectants
- Keep indoor humidity between 30-50%
- Practice regular cleaning routines
How Different Pathogens React to Cold Temperatures

Different pathogens respond to cold temperatures in unique ways that can affect their ability to spread and survive. Here’s how common disease-causing organisms react to cold:
- Viruses
- Flu viruses become more stable in cold air
- Rhinoviruses (common cold) thrive between 33-35°F
- COVID-19 can survive longer in cooler conditions
- Bacteria
- Most bacteria slow their growth below 40°F
- Some harmful bacteria remain dormant but viable
- E. coli can survive freezing temperatures
- Fungi
- Growth typically slows at temperatures under 50°F
- Spores can remain dormant until conditions improve
- Some species continue growing even near freezing
According to Dr. Sarah Chen, microbiologist at Stanford University, “Cold temperatures don’t kill most pathogens – they simply slow their metabolism and reproduction rates, allowing for extended survival periods.”
Effective Methods for Indoor Germ Control
Since cold temperatures alone won’t eliminate indoor germs effectively, you’ll need to implement multiple proven sanitization methods to maintain a healthy home environment.
To control germs indoors, follow these essential germicidal practices:
- Clean and disinfect high-touch surfaces daily using EPA-registered products
- Run HEPA air purifiers in main living areas for 12 hours per day
- Maintain indoor humidity between 30-50% to inhibit microbial growth
- Install UV-C sanitizing lights in HVAC systems
Proper indoor ventilation plays an important role in reducing airborne pathogens. “Opening windows for 15 minutes, three times daily creates significant air exchange that dilutes indoor contaminants,” explains Dr. Sarah Chen, indoor air quality specialist. You’ll also want to:
- Replace HVAC filters every 60-90 days
- Use exhaust fans while cooking and showering
- Keep indoor CO2 levels below 1000 ppm
The Role of Humidity in Germ Survival
Humidity levels play an essential role in determining how long viruses and bacteria can survive in your indoor environment. Most germs thrive in relative humidity between 40-60%, while very low or very high humidity can help reduce germ survival rates.
To maintain ideal humidity for minimizing germ growth:
- Keep indoor humidity between 30-50%
- Use a hygrometer to monitor levels
- Run dehumidifiers in damp spaces
- Add humidifiers during dry winter months
Different pathogens respond differently to humidity:
- Influenza viruses survive longer in dry air (below 40%)
- Bacteria prefer moist conditions (above 60%)
- Dust mites multiply rapidly above 50%
You’ll want to balance humidity control with other factors like temperature and ventilation to create the healthiest possible indoor environment. Consider using smart humidity monitors for consistent tracking.
Best Practices for Winter Home Sanitization
While cold temperatures alone don’t eliminate all germs, you’ll need a thorough winter sanitization strategy to keep your home healthy during indoor months. Focus your winter cleaning on these key germ hotspots:
- Wipe doorknobs, light switches, and remotes daily with EPA-registered disinfectants
- Sanitize kitchen counters and bathroom surfaces twice weekly
- Wash bedding in hot water (130°F minimum) every 7-10 days
- Vacuum carpets with HEPA filters weekly to remove trapped particles
“Regular disinfection of high-touch surfaces reduces viral and bacterial transmission by up to 90%,” notes Dr. Sarah Chen, infectious disease specialist. Don’t forget to ventilate your home for 15 minutes daily, even in winter, to reduce airborne pathogens. Maintain indoor humidity between 30-50% using a humidifier to discourage germ survival.
Alternative Ways to Maintain a Germ-Free Environment
Beyond traditional cleaning methods, you’ll find several natural and eco-friendly alternatives to maintain a germ-free home environment. Consider these proven options:
- Use vinegar solutions (1 cup vinegar per gallon of water) to disinfect surfaces naturally
- Place bowls of activated charcoal around your home to absorb airborne bacteria
- Diffuse tea tree or eucalyptus essential oils for their antimicrobial properties
“Natural disinfectants can be just as effective as chemical cleaners when used properly,” says Dr. Sarah Chen, environmental health specialist. Establish a regular cleaning schedule that includes:
- Weekly steam-cleaning of high-touch surfaces
- Monthly deep-cleaning with natural alternatives
- Daily ventilation of rooms for 15-20 minutes
Remember to rotate your natural cleaning solutions every few months to prevent bacterial resistance and maintain effectiveness.
Frequently Asked Questions
Can Opening Windows in Winter Reduce Airborne Viruses From Indoor Pets?
Like clearing smoke from a room, opening windows in winter can help reduce pet dander and virus transmission by diluting indoor air with fresh outdoor air, making it harder for pathogens to spread.
Does Running Air Conditioning Affect Dust Mite Populations Differently Than Cold Weather?
Your air conditioning’s impact on dust mites isn’t like cold weather. While AC reduces humidity, which helps limit dust mite populations, it won’t eliminate them as effectively as dehumidifiers would.
How Long Should Windows Stay Open to Effectively Circulate Cold Air?
On a typical winter morning, you’ll want to keep windows open for 10-15 minutes to achieve effective window ventilation. If you’re letting cold air circulate longer, watch your home’s temperature carefully.
Do Air Purifiers Work Better in Cold or Warm Temperatures?
Your air purifier’s performance isn’t greatly affected by temperature, but you’ll get better air quality in moderate temperatures since extreme cold or heat can impact airflow and filtration efficiency.
Can Cold Drafts From Windows Help Eliminate Cooking Odors and Bacteria?
While cold drafts can help with odor removal by creating air circulation, they’re not very effective at eliminating bacteria. You’ll get better results using proper ventilation and exhaust fans while cooking.


